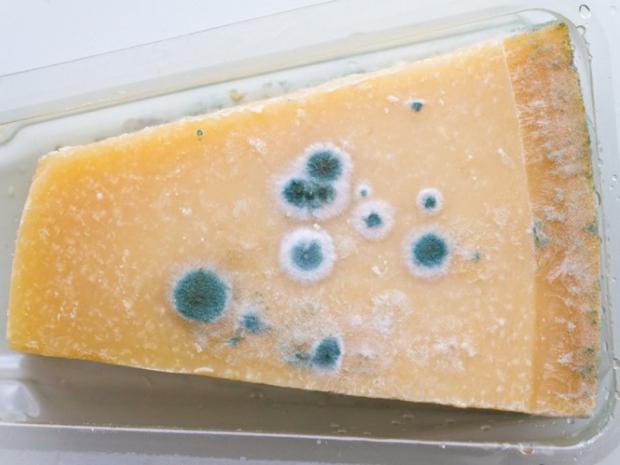

Schimmels op je voedsel? In veel gevallen wegsnijden voldoende
- News
- Schimmels op je voedsel? In veel gevallen wegsnijden voldoende
Het is je vast wel voorgekomen: beschimmelde voedsel. 'Bah, weg ermee!' zal je waarschijnlijk gedacht hebben. Maar niet alle schimmels zijn gevaarlijk. Sommigen zijn nuttig en smaken zelfs goed. Zie hier welke voedingsmiddelen eetbaar blijven en welke wél echt in zijn geheel weggegooid moeten worden.
slechts wegsnijden:
Groenten en (hard) fruit
Schimmels op groenten en (hard) fruit met een relatief laag vochtgehalte kunnen worden weggesneden. Denk aan kool, wortel en paprika. Ronde plekken op bijvoorbeeld sinaasappels moeten ruim afgesneden worden.
Harde kaas
Ook de schimmels op harde kaas moeten aan de buitenkant ruim worden weggesneden. Hetzelfde geldt voor blauwschimmelkazen zoals roquefort, gorgonzola en stilton. Als de kaas niet goed is verpakt, kan ook bacteriegroei ontstaan.
Gedroogde worst/ham
Schimmel is normaal op gedroogde worst en gedroogde ham. Ze zijn namelijk houdbare producten. Eventueel hoeven alleen de plekken weggesneden of afgeborsteld te worden.
direct weggooien:
Kliekjes
Kliekjes zoals stukjes vlees, stoofschotels en stamppotten, gekookte rijst of pasta kunnen direct worden weggegooid.
Gebakken etenswaren
Gebakken etenswaren zoals gebak, koekjes en brood moeten direct worden weggegooid. Schimmel kan bij droog, poreus voedsel verder zijn verspreid.
Vloeibare melkproducten
Bij bijvoorbeeld yoghurt en zure room kunnen de schimmels diep doordringen en is de kans op bacteriegroei groter.
Smeersels
Onder andere appelmoes en jams moeten bij schimmel niet uitgeschept worden. Ze kunnen giftige mycotoxinen produceren. Een vergiftiging uit zich vooral in ernstige leveraandoeningen.
Voeding zonder conserveermiddel
Bij voeding gemaakt zonder conserveermiddelen zoals noten, peulvruchten, pindakaas of andere notenpasta's is het risico op schimmel hoog. Met verpakking en al moeten deze producten weggegooid worden.


